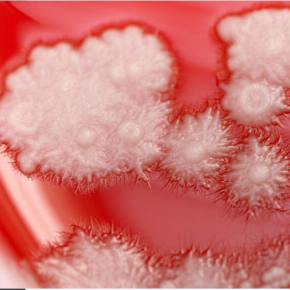

Comment une levure devient mycose ?
CNRS le journal
Biologie
En élucidant le mécanisme qui rend le champignon microscopique Candida albicans capable de provoquer des mycoses, une équipe de l'Institut de Biologie Valrose - iBV (CNRS/Inserm/UniCA), dirigée par Robert Arkowitz, directeur de recherche CNRS, ouvre la voie à de nouvelles pistes thérapeutiques.
Comment un champignon normalement inoffensif se transforme-t-il en un pathogène redoutable ? En étudiant les modifications morphologiques de Candida albicans, des chercheurs ont mis en évidence un mécanisme surprenant : la fluidification du cytoplasme jouerait un rôle critique dans l’infection.
Contact
Robert Arkowitz
Directeur de recherche CNRS à l'Institut de Biologie Valrose (iBV)